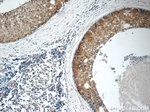
ARSB Antibody in Immunohistochemistry (Paraffin) (IHC (P))

Search
Proteintech
ARSB Polyclonal Antibody
{{$productOrderCtrl.translations['antibody.pdp.commerceCard.promotion.promotions']}}
{{$productOrderCtrl.translations['antibody.pdp.commerceCard.promotion.viewpromo']}}
{{$productOrderCtrl.translations['antibody.pdp.commerceCard.promotion.promocode']}}: {{promo.promoCode}} {{promo.promoTitle}} {{promo.promoDescription}}. {{$productOrderCtrl.translations['antibody.pdp.commerceCard.promotion.learnmore']}}
产品信息
13227-1-AP
种属反应
宿主/亚型
分类
类型
抗原
偶联物
形式
浓度
规格
纯化类型
保存液
内含物
保存条件
运输条件
产品详细信息
Immunogen sequence: LVFLLADDL GWNDVGFHGS RIRTPHLDAL AAGGVLLDNY YTQPLCTPSR SQLLTGRYQI RTGLQHQIIW PCQPSCVPLD EKLLPQLLKE AGYTTHMVGK WHLGMYRKEC LPTRRGFDTY FGYLLGSEDY YSHERCTLID ALNVTRCALD FRDGEEVATG YKNMYSTNIF TKRAIALITN HPPEKPLFLY LALQSVHEPL QVPEEYLKPY DFIQDKNRHH YAGMVSLMDE AVGNVTAALK SSGLWNNTVF IFSTDNGGQT LAGGNNWPLR GRKWSLWEGG VRGVGFVASP LLKQKGVKNR ELIHISDWLP TLVKLARGHT NGTKPLDGFD VWKTISEGSP SPRIELLHNI DPNFVDSSPY WPECSLLL (47-413 aa encoded by BC029051 )
靶标信息
Arylsulfatase B encoded by this gene belongs to the sulfatase family. The arylsulfatase B homodimer hydrolyzes sulfate groups of N-Acetyl-D-galactosamine, chondriotin sulfate, and dermatan sulfate. The protein is targetted to the lysozyme. Mucopolysaccharidosis type VI is an autosomal recessive lysosomal storage disorder resulting from a deficiency of arylsulfatase B. Two alternatively spliced transcript variants encoding distinct isoforms have been found for this gene.
仅用于科研。不用于诊断过程。未经明确授权不得转售。
生物信息学
蛋白别名: Arylsulfatase B; Arylsulfatase B (MPS VI); arylsulfatase B complex; arylsulfatase B precursor; arylsulfatase B precursor (EC 3.1.6.1); arylsulfatase B regulation; arylsulfatase B structural; arylsulfatase B temporal regulation; ASB; G4S; N-acetylgalactosamine-4-sulfatase; unnamed protein product
基因别名: 1110007C02Rik; AI480648; ARSB; As-1; As-1r; As-1s; As-1t; As1; As1-r; As1-s; As1-t; ASB; Asr-1; Ast-1; G4S; MPS6
UniProt ID: (Human) P15848, (Rat) P50430, (Mouse) P50429
Entrez Gene ID: (Human) 411, (Rat) 25227, (Mouse) 11881